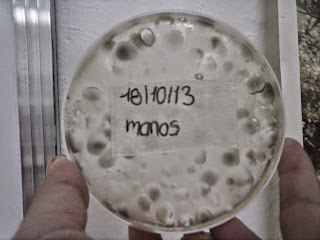

¡Los resultados que obtuvimos fueron increíbles!
Observen como, en pocos días crecieron un montón de cosas feas en las muestras de diferentes superficies que estudiamos.
Además probamos lo importante que es el flúor para nuestros dientes ya que los protege, cómo lo hizo con esta cáscara de huevo, de la acción de los ácidos (vinagre)
Por último, nos agregamos unas gotas de colorante vegetal para poner al descubierto a nuestra enemiga secreta: la placa dental. Y miren cómo la conseguimos...